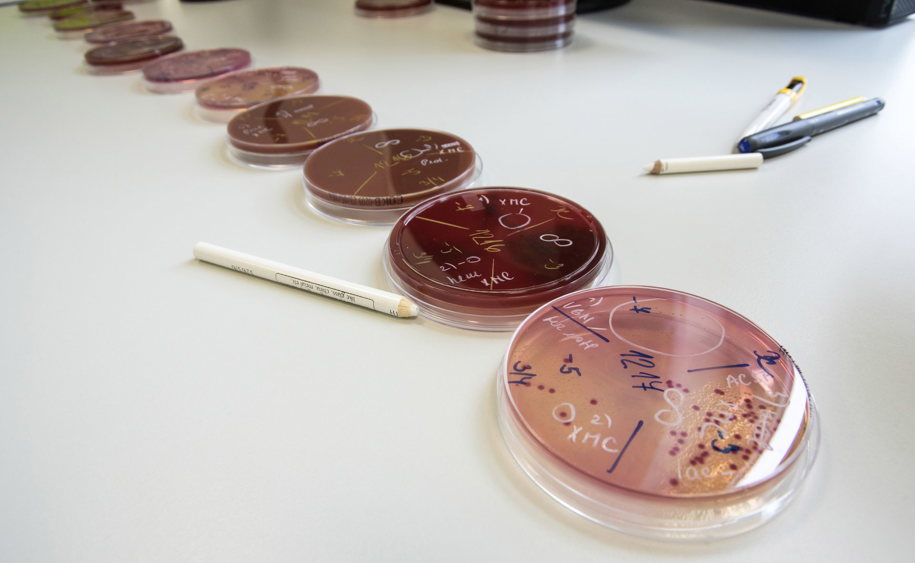

Laboratoř klinické mikrobiologie
Antibiotické středisko Ostrava
Antibiotické středisko je součástí laboratoře klinické mikrobiologie. V rámci ATB střediska vyšetřujeme mechanismy rezistence bakteriálních původců infekčních onemocnění. Provádíme konzultační činnost, která zahrnuje klinickou interpretaci výsledků a výběr racionální antibiotické terapie. Sledujeme a analyzujeme vývoj rezistence nozokomiálních i komunitních patogenů. Účastníme se celonárodních studií a spolupracujeme s Národní referenční laboratoří pro antibiotika.
Umístění pracoviště
budova PRIMECELL, areál FNO
Provozní doba střediska
Po - Pá 9.30 - 12:00 a 13.00 - 15.00 hodin
So a svátky - v naléhavých případech možno volat kdykoli.
Pohotovost
V naléhavých případech volejte kdykoli.
ATB středisko Ostrava
MUDr. Blanka Ochvatová
Konzultace antibiotické terapie
MUDr. Daniel Pařízek